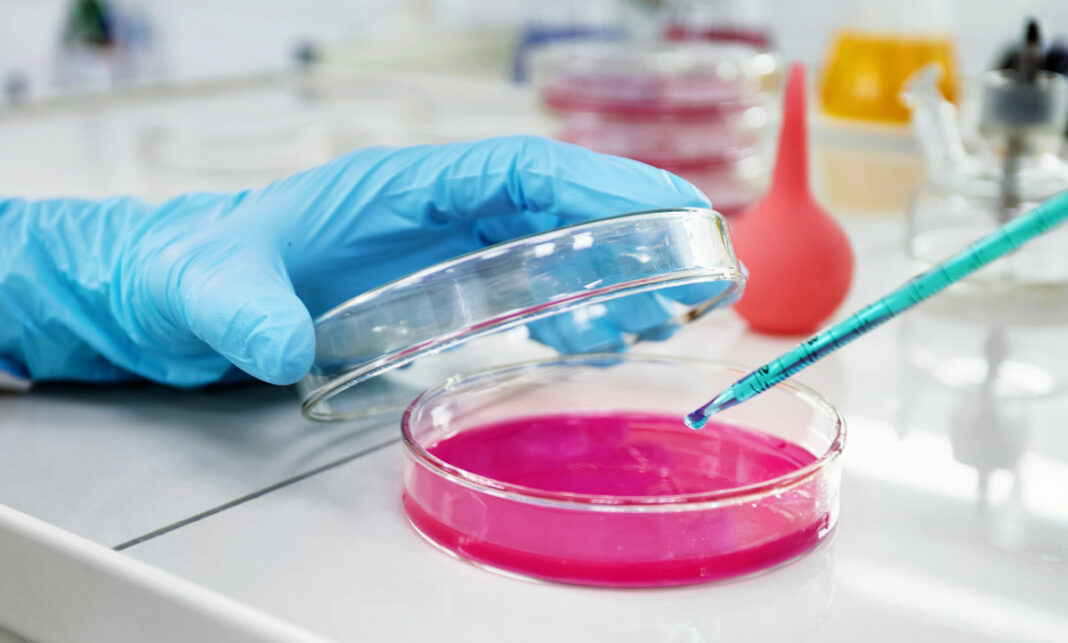
scientific experiment in laboratory лаборатория

Федеральный исследовательский центр Фундаментальной и трансляционной медицины (ФИЦ ФТМ) в Новосибирске намерен аккредитовать лабораторию для работы с опасными высокопатогенными вирусами в середине 2023 года. Это позволит приступить к полноценным исследованиям в новом вирусологическом корпусе, рассказал замдиректора центра по развитию Илья Деулин.
В мае руководитель отдела стратегического развития ФИЦ ФТМ Юрий Хрипко сообщил, что центр завершил строительство нового корпуса, где расположится лаборатория для работы с опасными вирусами. По его словам:
Конечно, сейчас будет аккредитация этих помещений, то есть получение [разрешения на работу с вирусами] второй группы патогенности. Это займет чуть больше времени, но мы планируем к середине следующего года.
Как уточнили в пресс-службе ФИЦ, аккредитация помещений необходима, чтобы показать, что они защищены и что там есть сертифицированное оборудование.
Илья Деулин подчеркнул, что новая лаборатория будет абсолютно уникальной, подобных ей нет за Уралом. По его словам, сотрудники вирусологической лаборатории будут заниматься прикладными научными исследованиями при взаимодействии с международными партнерами.
Юрий Хрипко ранее рассказывал, что корпус необходим центру для проведения экспериментов на животных, а также проведения работы с накоплением вируса в соответствии с нормами и правилами для этого.
Новый корпус учреждения для работы с инфекциями будет модульного типа. В лаборатории корпуса будут проводить работы по испытанию биологических препаратов, средств дезинфекции, испытания противовирусных препаратов, мониторинг, разработка вакцин. Работать в новом корпусе будут сотрудники существующих структур, в частности Института зоонозных инфекций.